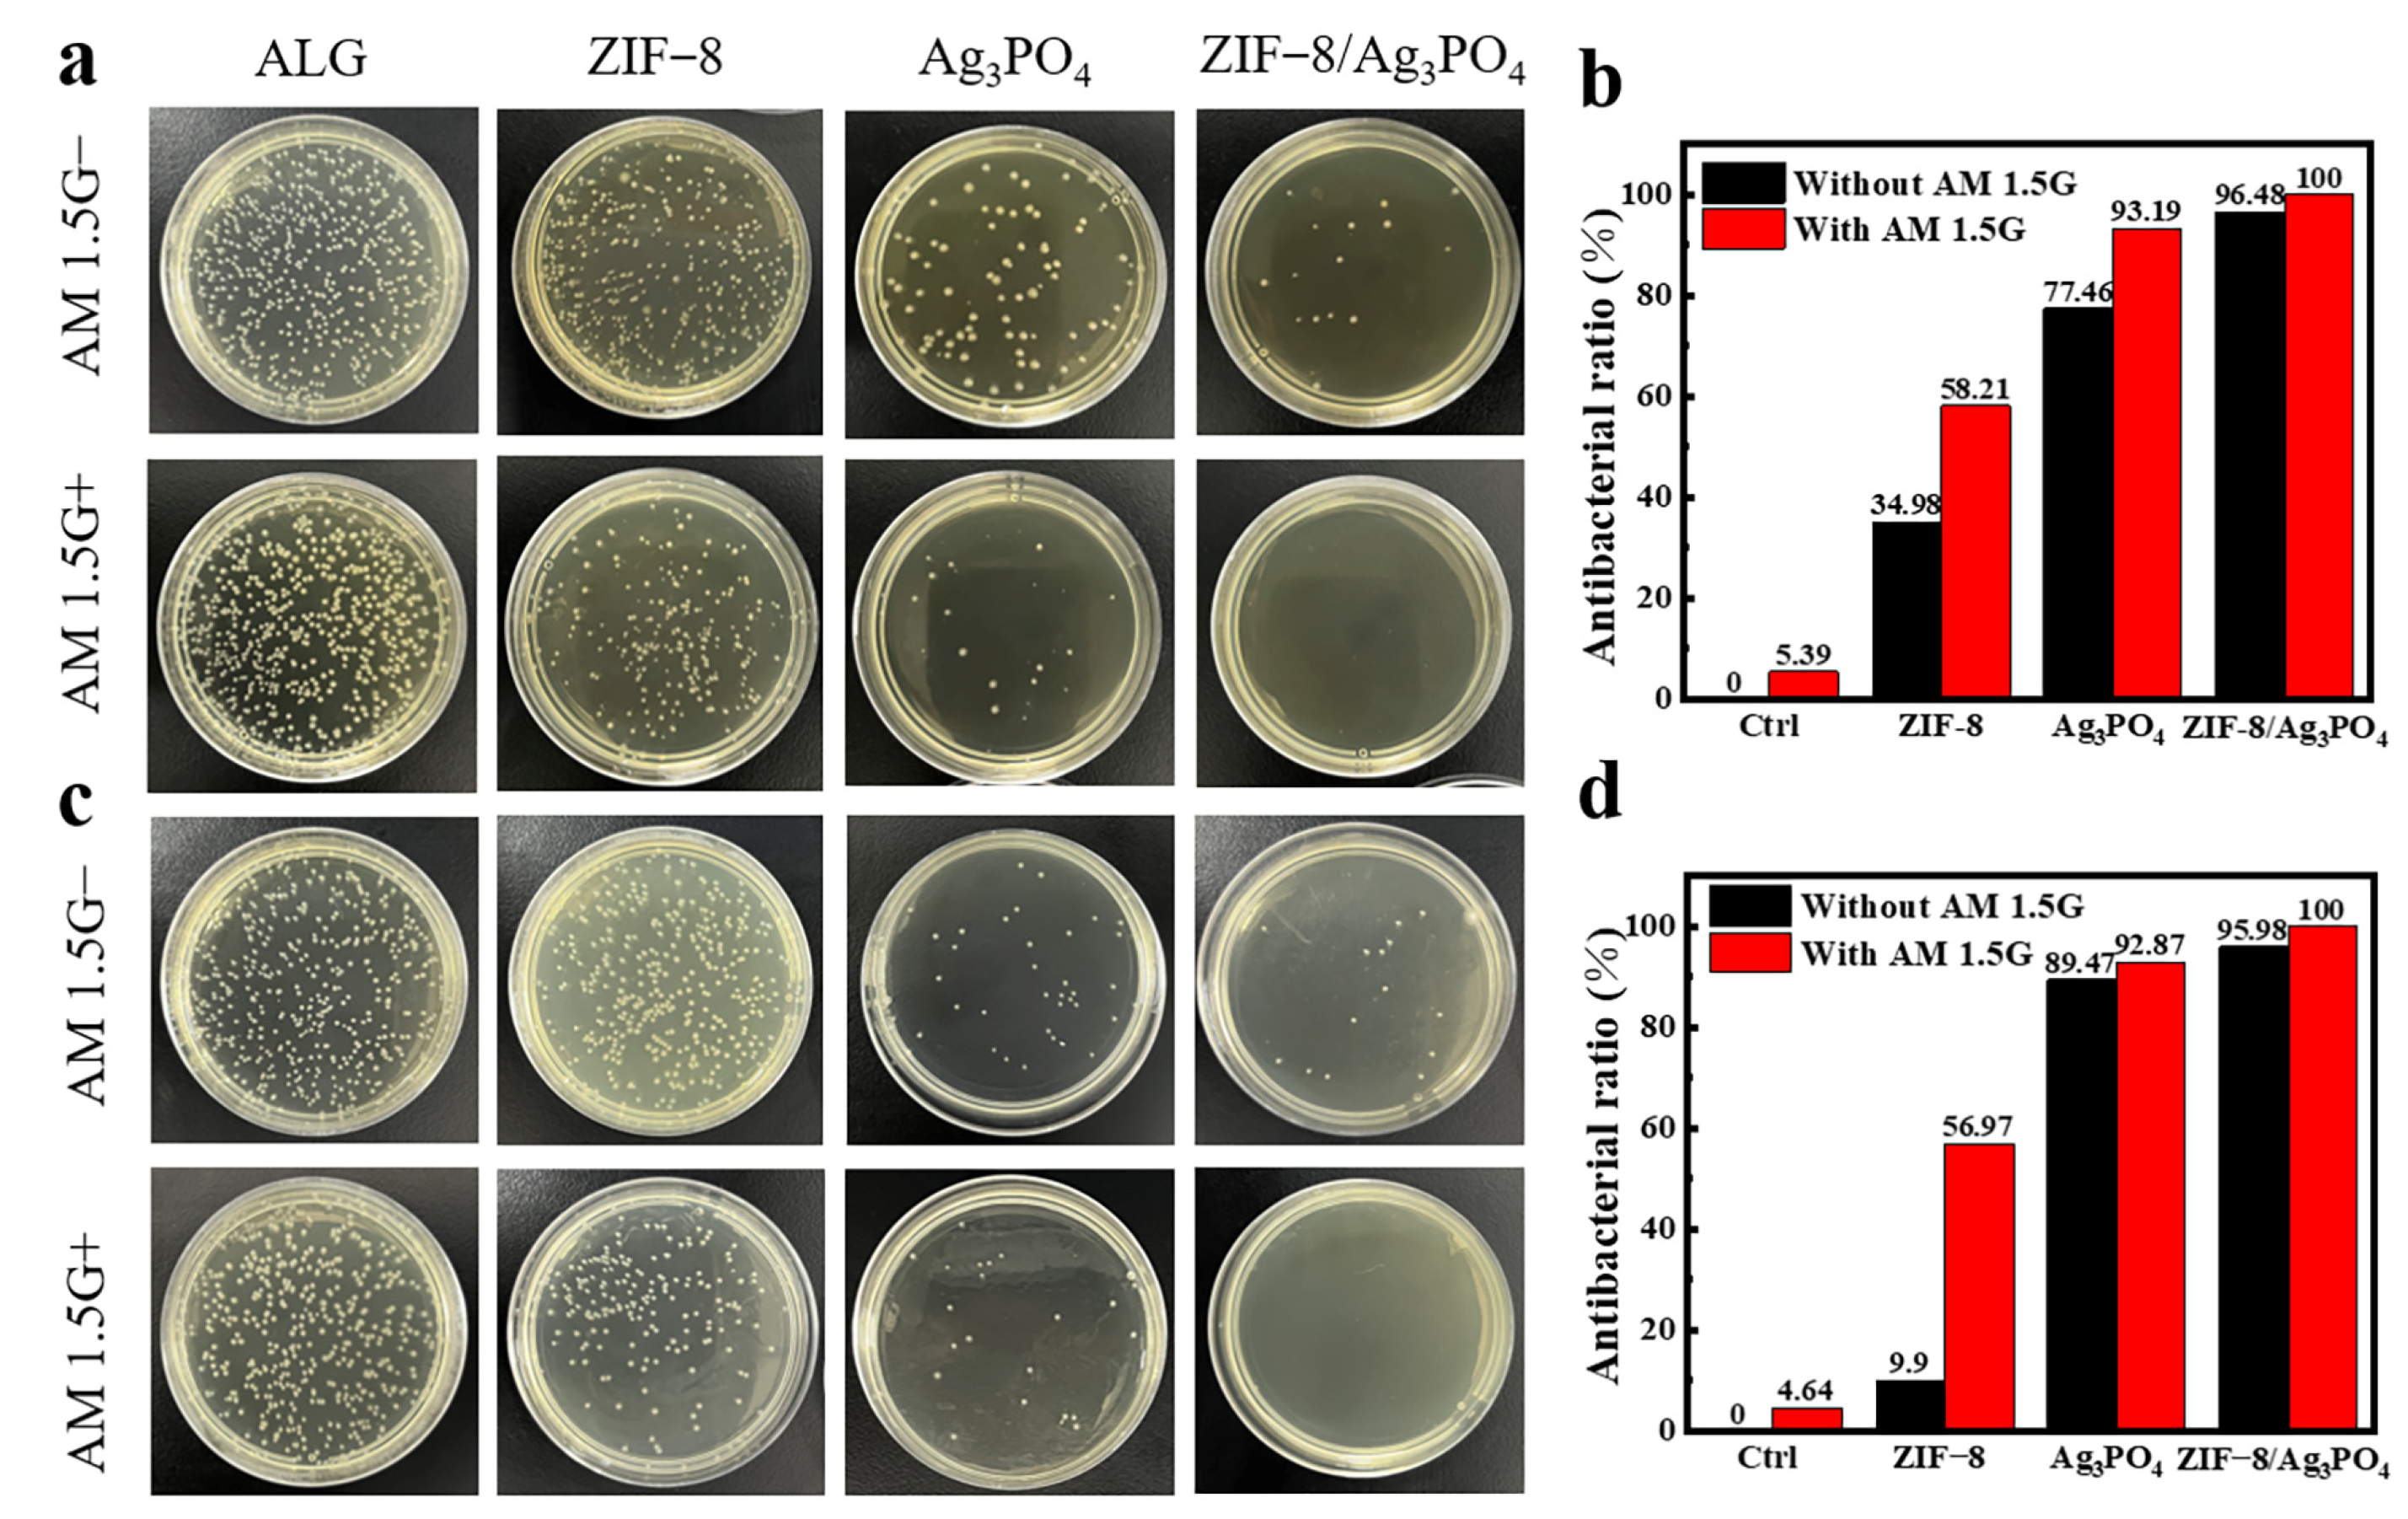
Materials 18 02544 g009

Z-Scheme ZIF-8/Ag3PO4 Heterojunction Photocatalyst for High-Performance Antibacterial Food Packaging Films
Abstract
1. Introduction
2. Materials and Methods
2.1. Materials
2.2. Characterization
2.3. Preparation of ZIF-8
2.4. Preparation of ZIF-8/Ag3PO4 Composite Material
2.5. Preparation of ZIF-8/Ag3PO4 Composite Film
2.6. Antibacterial Experiments
2.7. Practical Application of Antimicrobial Food Packaging Film
3. Results and Discussions
3.1. ZIF-8/Ag3PO4 Composite Preparation and Characterization
3.2. Detection of Reactive Oxygen Species
3.3. Assessment of Membrane Permeability
3.4. Microbial ATP Assay
3.5. Staining of Live/Dead Bacteria
3.6. Antibacterial Performance
3.7. Practical Application as Food Packaging Film
3.8. Mechanism Analysis
4. Conclusions
Supplementary Materials
Author Contributions
Funding
Institutional Review Board Statement
Informed Consent Statement
Data Availability Statement
Conflicts of Interest
References
- Fahmy, H.M.; Eldin, R.E.S.; Serea, E.S.A.; Gomaa, N.M.; AboElmagd, G.M.; Salem, S.A.; Elsayed, Z.A.; Edrees, A.; Shams-Eldin, E.; Shalan, A.E. Advances in nanotechnology and antibacterial properties of biodegradable food packaging materials. RSC Adv. 2020, 10, 20467–20484. [Google Scholar] [CrossRef] [PubMed]
- Liu, Y.; Blanco-Toral, C.; Larrouy-Maumus, G. The role of cyclic nucleotides in bacterial antimicrobial resistance and tolerance. Trends Microbiol. 2024, 33, 164–183. [Google Scholar] [CrossRef] [PubMed]
- Guan, G.; Zhang, L.; Zhu, J.; Wu, H.; Li, W.; Sun, Q. Antibacterial properties and mechanism of biopolymer-based films functionalized by CuO/ZnO nanoparticles against Escherichia coli and Staphylococcus aureus. J. Hazard. Mater. 2021, 402, 123542. [Google Scholar] [CrossRef]
- Haider, M.S.; Shao, G.N.; Imran, S.; Park, S.S.; Abbas, N.; Tahir, M.S.; Hussain, M.; Bae, W.; Kim, H.T. Aminated polyethersulfone-silver nanoparticles (AgNPs-APES) composite membranes with controlled silver ion release for antibacterial and water treatment applications. Mater. Sci. Eng. C 2016, 62, 732–745. [Google Scholar] [CrossRef]
- Fang, Z.; Liu, Y.; Qi, J.; Yu, M.; Wang, Y.; Qiu, Y.; Ma, Z.; Liu, S. Dual photothermal-photocatalytic Au@ZIF-8/Ti3C2Tx nanocomposite for enhanced solar steam sterilization and biofouling-resistant hydrogel membrane. Mater. Today Chem. 2025, 43, 102467. [Google Scholar] [CrossRef]
- Du, Y.; Guo, Q.; Wu, Y.; Zhang, K.; Duan, L.; Zhang, L.; Tang, H.; Shang, J.; Peng, Y.; Li, Z. 0D/2D Z-schemed carbon nitride quantum dots/Bi2MoO6−x with enhanced carriers’ separation efficiency toward oxidation coupling of amines under ambient conditions. Appl. Surf. Sci. 2023, 619, 156736. [Google Scholar] [CrossRef]
- Xiao, R.; Zhang, J.; Jiang, T.; Zhou, Y.; Wang, Y.; Xu, W.; Feng, Y. Highly ordered Janus CdS-Au-TiO2 Z-scheme structure with high efficiency in photocatalysis. Sci. China Chem. 2023, 66, 1722–1730. [Google Scholar] [CrossRef]
- Ahmad, N.; Nordin, N.A.H.M.; Jaafar, J.; Malek, N.A.N.N.; Ismail, A.F.; Ramli, M.K.N. Modification of zeolitic imidazolate framework-8 with amine groups for improved antibacterial activity. Mater. Today Proc. 2021, 46, 2024–2029. [Google Scholar] [CrossRef]
- Li, H.; Tu, W.; Zhou, Y.; Zou, Z. Z-Scheme photocatalytic systems for promoting photocatalytic performance: Recent progress and future challenges. Adv. Sci. 2016, 3, 1500389. [Google Scholar] [CrossRef]
- Parida, V.K.; Dhakad, R.; Chowdhury, S.; Gupta, A.K. Facile synthesis of a 2D/3D Z-scheme Cu-g-C3N4/BiOBr heterojunction for enhanced photocatalytic degradation of ciprofloxacin under visible light irradiation. J. Environ. Chem. Eng. 2023, 11, 111569. [Google Scholar] [CrossRef]
- Liu, N.; Zhang, J.; Wang, Y.; Zhu, Q.; Zhang, X.; Duan, J.; Hou, B. Novel MOF-based photocatalyst AgBr/AgCl@ZIF-8 with enhanced photocatalytic degradation and antibacterial properties. Nanomaterials 2022, 12, 1946. [Google Scholar] [CrossRef] [PubMed]
- Abdi, J. Synthesis of Ag-doped ZIF-8 photocatalyst with excellent performance for dye degradation and antibacterial activity. Colloids Surf. Physicochem. Eng. Aspects 2020, 604, 125330. [Google Scholar] [CrossRef]
- Nguyen, H.C.; Le, P.D.; Cao, T.M.; Van Pham, V. Establishing Z-scheme Bi2WO6/g-C3N4 interfaces toward efficient photocatalytic performance of NOx under visible light. J. Alloys Compd. 2024, 989, 174244. [Google Scholar] [CrossRef]
- Xu, X.; Zhang, J.; Tao, F.; Dong, Y.; Wang, L.; Hong, T. Facile construction of Z-scheme g-C3N4/BiVO4 heterojunctions for boosting visible-light photocatalytic activity. Mater. Sci. Eng. B 2022, 279, 115676. [Google Scholar] [CrossRef]
- Shen, B.; Wang, B.; Zhu, L.; Jiang, L. Properties of cobalt-and nickel-doped ZIF-8 framework materials and their application in heavy-metal removal from wastewater. Nanomaterials 2020, 10, 1636. [Google Scholar] [CrossRef]
- Wu, M.; Chen, X.; Du, J.; Ye, J.; Ye, A.; Zhou, C.; Fu, Q. Derivative carbon particles with different sizes from ZIF-8 and their adsorption capacity for MB. J. Mater. Sci. 2023, 58, 2552–2569. [Google Scholar] [CrossRef]
- Dong, P.; Hou, G.; Liu, C.; Zhang, X.; Tian, H.; Xu, F.; Xi, X.; Shao, R. Origin of activity and stability enhancement for Ag3PO4 photocatalyst after calcination. Materials 2016, 9, 968. [Google Scholar] [CrossRef]
- Qasim, A.K. Novel Synthesis of Gold Doped Silver Phosphate Nanoparticles by Hydrothermal Method for The Enhancement of Visible Light-Responsive Photocatalytic Degradation of Fast Green FCF Dye. Sci. J. Univ. Zakho 2022, 10, 76–80. [Google Scholar] [CrossRef]
- Qin, L.; Tao, P.; Zhou, X.; Pang, Q.; Liang, C.; Liu, K.; Luo, X. Synthesis and characterization of high efficiency and stable spherical Ag3PO4 visible light photocatalyst for the degradation of methylene blue solutions. J. Nanomater. 2015, 2015, 258342. [Google Scholar] [CrossRef]
- Mroczkowska, M.; Nowinski, J.; Zukowska, G.; Mroczkowska, A.; Garbarczyk, J.; Wasiucionek, M. Micro Raman, FT-IR/PAS, XRD and SEM studies on glassy and partly crystalline silver phosphate ionic conductors. J. Power Sources 2007, 173, 729–733. [Google Scholar] [CrossRef]
- Botelho, G.; Sczancoski, J.C.; Andres, J.; Gracia, L.; Longo, E. Experimental and theoretical study on the structure, optical properties, and growth of metallic silver nanostructures in Ag3PO4. J. Phy. Chem. C 2015, 119, 6293–6306. [Google Scholar] [CrossRef]
- Kausor, M.A.; Chakrabortty, D. Optimization of system parameters and kinetic study of photocatalytic degradation of toxic acid blue 25 dye by Ag3PO4@ RGO nanocomposite. J. Nanopart. Res. 2020, 22, 93. [Google Scholar] [CrossRef]
- Wang, X.-H.; Wei, X.-F.; Liu, J.-H.; Yang, W.; Liu, Y.-A.; Cheng, K.; He, X.-Y.; Fu, X.-L.; Zhang, Y.; Zhang, H.-X. Chlorin e6-1, 3-diphenylisobenzofuran polymer hybrid nanoparticles for singlet oxygen-detection photodynamic abaltion. Methods Appl. Fluores. 2021, 9, 025003. [Google Scholar] [CrossRef] [PubMed]
- Smale, S.T. β-Galactosidase assay. Cold Spring Harb. Protoc. 2010, 2010, pdb-prot5423. [Google Scholar] [CrossRef]
- Bottari, B.; Santarelli, M.; Neviani, E. Determination of microbial load for different beverages and foodstuff by assessment of intracellular ATP. Trends Food Sci. Technol. 2015, 44, 36–48. [Google Scholar] [CrossRef]
- Tawakoli, P.; Al-Ahmad, A.; Hoth-Hannig, W.; Hannig, M.; Hannig, C. Comparison of different live/dead stainings for detection and quantification of adherent microorganisms in the initial oral biofilm. Clin. Oral Investig. 2013, 17, 841–850. [Google Scholar] [CrossRef]
- Liang, Y.; Zhao, Y.; Sun, H.; Dan, J.; Kang, Y.; Zhang, Q.; Su, Z.; Ni, Y.; Shi, S.; Wang, J. Natural melanin nanoparticle-based photothermal film for edible antibacterial food packaging. Food Chem. 2023, 401, 134117. [Google Scholar] [CrossRef]
- Zhao, X.; Chen, T.; Liu, J.; Wang, X.; Weng, Y. Development of antifouling antibacterial polylactic acid (PLA)-based packaging and application for chicken meat preservation. Food Chem. 2025, 463, 141116. [Google Scholar] [CrossRef]
- Li, L.-H.; Deng, J.-C.; Deng, H.-R.; Liu, Z.-L.; Xin, L. Synthesis and characterization of chitosan/ZnO nanoparticle composite membranes. Carbohydr. Res. 2010, 345, 994–998. [Google Scholar] [CrossRef]
- Salari, M.; Khiabani, M.S.; Mokarram, R.R.; Ghanbarzadeh, B.; Kafil, H.S. Development and evaluation of chitosan based active nanocomposite films containing bacterial cellulose nanocrystals and silver nanoparticles. Food Hydrocolloid. 2018, 84, 414–423. [Google Scholar] [CrossRef]
- Tekin, F.S.; Culfaz-Emecen, P.Z. Controlling cellulose membrane performance via solvent choice during precursor membrane formation. ACS Appl. Polym. Mater. 2023, 5, 2185–2194. [Google Scholar] [CrossRef]
- Cerveny, J.; Meyer, J.D.; Hall, P.A. Microbiological spoilage of meat and poultry products. In Compendium of the Microbiological Spoilage of Foods and Beverages; Springer: New York, NY, USA, 2009; pp. 69–86. [Google Scholar]
- Prasetyaningrum, A.; Utomo, D.P.; Raemas, A.F.A.; Kusworo, T.D.; Jos, B.; Djaeni, M. Alginate/κ-carrageenan-based edible films incorporated with clove essential oil: Physico-chemical characterization and antioxidant-antimicrobial activity. Polymers 2021, 13, 354. [Google Scholar] [CrossRef] [PubMed]
- Singh, S.; Maji, P.K.; Lee, Y.S.; Gaikwad, K.K. Applications of gaseous chlorine dioxide for antimicrobial food packaging: A review. Environ. Chem. Lett. 2021, 19, 253–270. [Google Scholar] [CrossRef]
- Liang, Y.; Shang, R.; Lu, J.; Liu, L.; Hu, J.; Cui, W. Ag3PO4@UMOFNs core–shell structure: Two-dimensional MOFs promoted photoinduced charge separation and photocatalysis. ACS Appl. Mater. Interfaces 2018, 10, 8758–8769. [Google Scholar] [CrossRef]
- Sies, H.; Belousov, V.V.; Chandel, N.S.; Davies, M.J.; Jones, D.P.; Mann, G.E.; Murphy, M.P.; Yamamoto, M.; Winterbourn, C. Defining roles of specific reactive oxygen species (ROS) in cell biology and physiology. Nat. Rev. Mol. Cell Biol. 2022, 23, 499–515. [Google Scholar] [CrossRef]
- Aguilar-Garay, R.; Lara-Ortiz, L.F.; Campos-López, M.; Gonzalez-Rodriguez, D.E.; Gamboa-Lugo, M.M.; Mendoza-Pérez, J.A.; Anzueto-Ríos, Á.; Nicolás-Álvarez, D.E. A comprehensive review of silver and gold nanoparticles as effective antibacterial agents. Pharmaceuticals 2024, 17, 1134. [Google Scholar] [CrossRef]
- Chandraker, S.K.; Kumar, R. Biogenic biocompatible silver nanoparticles: A promising antibacterial agent. Biotechnol. Genet. Eng. Rev. 2024, 40, 3113–3147. [Google Scholar] [CrossRef]
- Chi, L.; Qi, J.; Ma, Z.; Zhang, Z.; Qiu, Y.; Sun, T.; Liu, S. Multimodal Synergistic Antimicrobial Activity of the Copper-Doped and Oxygen-Defective In Situ Nanocoating on Medical Titanium. ACS Appl. Bio Mater. 2025, 8, 3560–3570. [Google Scholar] [CrossRef]

Disclaimer/Publisher’s Note: The statements, opinions and data contained in all publications are solely those of the individual author(s) and contributor(s) and not of MDPI and/or the editor(s). MDPI and/or the editor(s) disclaim responsibility for any injury to people or property resulting from any ideas, methods, instructions or products referred to in the content. |
© 2025 by the authors. Licensee MDPI, Basel, Switzerland. This article is an open access article distributed under the terms and conditions of the Creative Commons Attribution (CC BY) license (https://creativecommons.org/licenses/by/4.0/).
Share and Cite
Zhou, Q.; Fang, Z.; Wang, J.; Zhang, W.; Liu, Y.; Yu, M.; Ma, Z.; Qiu, Y.; Liu, S. Z-Scheme ZIF-8/Ag3PO4 Heterojunction Photocatalyst for High-Performance Antibacterial Food Packaging Films. Materials 2025, 18, 2544. https://doi.org/10.3390/ma18112544
Zhou Q, Fang Z, Wang J, Zhang W, Liu Y, Yu M, Ma Z, Qiu Y, Liu S. Z-Scheme ZIF-8/Ag3PO4 Heterojunction Photocatalyst for High-Performance Antibacterial Food Packaging Films. Materials. 2025; 18(11):2544. https://doi.org/10.3390/ma18112544
Chicago/Turabian StyleZhou, Qingyang, Zhuluni Fang, Junyi Wang, Wenbo Zhang, Yihan Liu, Miao Yu, Zhuo Ma, Yunfeng Qiu, and Shaoqin Liu. 2025. "Z-Scheme ZIF-8/Ag3PO4 Heterojunction Photocatalyst for High-Performance Antibacterial Food Packaging Films" Materials 18, no. 11: 2544. https://doi.org/10.3390/ma18112544
APA StyleZhou, Q., Fang, Z., Wang, J., Zhang, W., Liu, Y., Yu, M., Ma, Z., Qiu, Y., & Liu, S. (2025). Z-Scheme ZIF-8/Ag3PO4 Heterojunction Photocatalyst for High-Performance Antibacterial Food Packaging Films. Materials, 18(11), 2544. https://doi.org/10.3390/ma18112544







